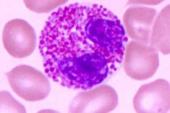
用“细致入微”造句

- 1、家属于离开家的人,因为他需要家温暖的照顾和细心的体贴;家属于失去家的人,因为他需要家的激励与鼓舞;家属于刚刚失败的人,因为他需要家的拥护与开拓……2、爱情中需要有一种软弱无力的感觉,要有体贴爱护
- 一、老王的生花妙笔,把每个角色都刻划得栩栩如生。二、现代通讯系统的历史,早已刻划了惊人的真知灼见。三、这部小说力透纸背地刻划了人性的光明与坚强。四、这部小说力争上游地刻划了人性的光明与坚强。五、岁月
- 1、别太好人,别太细致入微,别爱得太明显,妈妈就是因为这样,才让儿女们有恃无恐。2、设计人员借助先进的工具能够生成赏心悦目、细致入微的图像,并将其用在Web站点,让人耳目一新。3、而草堂期形成的萧淡
- 一、要想自己成为幸福的人,就应当对别人关怀备至,体贴入微,赤诚相见。苏霍姆林斯基 二、体贴入微:体贴,细心体谅别人的心情和处境,给予关心和照顾;入微,达到细微的程度。形容对人照顾或关怀非常细心、周到
- (1) 三人关系刻划入微,影片有种令人想入非非的奇异魅力。(2) 院体花鸟画在造型上的确讲求刻划入微,然而形似的内涵绝非就意味着标本式的结构名件。(3) 统传题材的红楼梦、白蛇传、天女散花、嫦娥奔月
- 一、他在二十世纪六十年代发表的短篇作品,都是观察入微的妙品.二、咬字清晰、表达能力强、观察入微、处事冷静、勇于向陌生人说话,及关心社会,都是成为小主播的条件。三、真正的高手对于身周的变化均能观察入微
- 1、假如你观察得极其精细入微,并把你所见的情景相当如实地描绘下来,结果画布上的景色就会惊人的逼真。2、他提倡“学不离乐”,同时也强调精细入微的学习。3、这些荧光色调传递了各种精细入微的情绪,就像一种